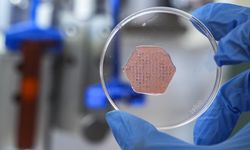
Klasik yara bantları tarihe karışıyor! İzmir’den probiyotikli devrim

İzmir’in Seferihisar ilçesi açıklarında, Sahil Güvenlik Komutanlığı’na yapılan ihbar doğrultusunda harekete geçildi. Lastik botta bulunan bir grup düzensiz göçmenin, Yunanistan tarafından Türk kara sularına itilmesi üzerine, bölgeye hızlıca ekipler yönlendirildi.
Yunanistan unsurlarının ittiği botta 35 göçmen bulundu
Sahil Güvenlik ekipleri, Yunan unsurlarınca Türk kara sularına itilen lastik botu tespit etti. Yapılan operasyonda, aralarında 8 çocuk bulunan 35 düzensiz göçmen güvenli bir şekilde kurtarıldı.

Bir diğer lastik bot durduruldu, göçmenler yakalandı
Aynı bölgedeki bir başka lastik bot da, Sahil Güvenlik gemisi tarafından durduruldu. Botta bulunan 16'sı çocuk olmak üzere toplam 35 düzensiz göçmen, Sahil Güvenlik ekipleri tarafından yakalanarak işlemleri için karaya çıkarıldı.
Göçmenler İl Göç İdaresi Müdürlüğüne teslim edildi
Yakalanan düzensiz göçmenler, gerekli işlemlerinin ardından İl Göç İdaresi Müdürlüğüne teslim edilerek, süreçlerine devam edilmek üzere ilgililere bildirildi.